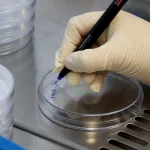

کنترل کیفیت محصولات آسپتیک: فرآیند دقیق و استاندارد در شرکت فرآورده بافت ایرانیان

- نویسنده: Adel Marzban
- آموزش
- 5 (2)
محصولات آسپتیک (Aseptic) مانند تاندون و دریچههای قلب، به دلیل ماهیت حساس و حیاتیشان، نیازمند فرآیندهای کنترل کیفیت بسیار دقیق و پیچیدهای هستند. این محصولات در محیطی استریل تولید میشوند و بدون استریلیزاسیون نهایی به دست مصرفکننده میرسند. بنابراین، کوچکترین خطا در فرآیند تولید میتواند عواقب جدی برای بیماران به همراه داشته باشد. شرکت فرآورده بافت ایرانیان با بهکارگیری فناوریهای پیشرفته و رعایت استانداردهای بینالمللی، محصولات آسپتیک با کیفیت بالا و ایمن را تحت نام تجاری Regen Allograft تولید میکند. این محصولات در حوزههای پزشکی ورزشی، ارتوپدی و جراحیهای قلب و عروق کاربرد گستردهای دارند. در ادامه، به معرفی برخی از محصولات آسپتیک این شرکت میپردازیم.
آلوگرفتهای تاندون و مینیسک
آسیبهای تاندون، لیگامان و رباط از جمله چالشهای مهم در جراحیهای ارتوپدی و پزشکی ورزشی هستند. در چنین مواردی، جراحان نیاز به جایگزینی بافت آسیبدیده با بافتی سالم و عملکردی دارند. آلوگرافتهای تاندون و مینیسک تولیدی شرکت فرآورده بافت ایرانیان با نام تجاری Regen Allograft، راهحلی ایمن و مؤثر برای این نیازها ارائه میدهند.
ویژگیهای کلیدی آلوگرفتهای تاندون و مینیسک
فرآوری آسپتیک: این محصولات به روش آسپتیک فرآوری میشوند و در طول فرآیند تولید، کیفیت و یکپارچگی بافت به دقت پایش میشود.
کاربرد در جراحیهای پزشکی ورزشی: این آلوگرفتها در جراحیهایی مانند بازسازی ACL،PCL و منیسکتومی توتال و ساب توتال استفاده میشوند. این آلوگرفتها انقلابی در تکنیکهای جراحی ارتوپدی ایجاد کردهاند و مزایای قابل توجهی در بازسازی تاندون و لیگامان ارائه میدهند.
انواع محصولات تاندون و منیسک ریجن (Regen Allograft)
- Achilles Tendon
- Tibialis Anterior Tendon
- Tibialis Posterior Tendon
- Other Tendons
- Meniscus
آلوگرفت دریچه قلب
دریچههای قلب آسیبدیده یا دارای نقص عملکرد، نیاز به جایگزینی یا ترمیم دارند. آلوگرافت دریچه قلب تولیدی شرکت فرآورده بافت ایرانیان (ریجن)، راهحلی ایمن و مؤثر برای این نیازهاست. این محصولات از بافت اهدایی دریچه قلب افراد تهیه میشوند و با استفاده از کوکتل آنتیبیوتیکی فرآوری میشوند.
کاربرد در جراحیهای قلب و عروق: این محصولات برای ترمیم بیماریهای مادرزادی، نارسایی دریچه قلب و جایگزینی دریچههای آسیبدیده استفاده میشوند.
این آلوگرفتها با داشتن ایمنی، اثربخشی و عملکرد مطلوب، گزینهای ایدهآل برای جراحیهای پیچیده قلب و عروق هستند.
انواع آلوگرفت دریچه قلب
- دریچه های قلب آئورت Aortic Heart Valve
- دریچه های قلب پولمونر Pulmonary Heart Valve
در این مقاله، به بررسی فرآیند کنترل کیفیت محصولات آسپتیک در شرکت فرآورده بافت ایرانیان میپردازیم و اهمیت پایش میکروبیولوژیکی را در این فرآیند بررسی خواهیم کرد.
خانم هاجر غریبی، کارشناس ارشد رشته میکروبیولوژی و سرپرست کنترل کیفیت محصولات شرکت فرآورده بافت ایرانیان، به طور جامع درباره فرآیندهای کنترل کیفیت محصولات آسپتیک توضیح میدهند. ایشان با اشاره به اهمیت پایش میکروبیولوژیکی در مراحل مختلف تولید، از نمونهگیری اولیه تا آزمایشهای نهایی محصول، بینش ارزشمندی را درباره استانداردهای دقیق و روشهای بهکاررفته در شرکت ارائه میدهند.
این ویدیو نه تنها برای متخصصان حوزه پزشکی و بیوتکنولوژی مفید است، بلکه به تمامی علاقهمندان به فرآیندهای کنترل کیفیت در تولید محصولات بیولوژیک کمک میکند تا با دقت و حساسیتهای این فرآیندها آشنا شوند. با تماشای این ویدیو، میتوانید از نزدیک شاهد تلاشهای بیوقفه تیم کنترل کیفیت شرکت فرآورده بافت ایرانیان برای ارائه محصولاتی ایمن و باکیفیت باشید.
اهمیت پایش میکروبیولوژیکی در محصولات آسپتیک
محصولات آسپتیک به دلیل عدم وجود فرآیند استریلیزاسیون نهایی، مستعد آلودگیهای میکروبی هستند. این آلودگیها میتوانند منجر به عفونتهای جدی در بیماران شوند. بنابراین، پایش میکروبیولوژیکی در تمام مراحل تولید، از ورود مواد اولیه تا عرضه محصول نهایی، از اهمیت بالایی برخوردار است.
در شرکت فرآورده بافت ایرانیان، کنترل کیفیت محصولات آسپتیک در دو مرحله اصلی انجام میشود:
- کنترل میکروبی در حین تولید
- کنترل کیفیت محصول نهایی قبل از عرضه
فرآیند کنترل کیفیت آلوگرافت آسپتیک
۱. کنترل میکروبی در حین تولید
فرآیند کنترل کیفیت در شرکت فرآورده بافت ایرانیان از همان ابتدای ورود نسوج به خط تولید آغاز میشود. این فرآیند شامل مراحل زیر است:
- نمونهگیری از محلول نگهدارنده نسوج: قبل از شروع فرآیند تولید، محلول نگهدارنده نسوج از نظر آلودگیهای میکروبی بررسی میشود.
- بررسی محیط تولید: محیط تولید مطابق با استانداردهای ISO پایش میشود تا از عدم وجود آلودگی اطمینان حاصل شود.
- تستهای بایوبوردن: این تستها برای شناسایی میکروارگانیسمهای احتمالی در محیط تولید انجام میشوند.
- فرآوری نسوج در کوکتل آنتیبیوتیکی: پس از فرآوری، نمونهگیری مجدد انجام میشود تا از عدم وجود آلودگی اطمینان حاصل شود.
۲. کنترل کیفیت محصول نهایی
پس از اتمام فرآیند تولید، محصول نهایی قبل از بستهبندی تحت آزمایشهای دقیق میکروبیولوژیکی قرار میگیرد. این آزمایشها شامل موارد زیر هستند:
- تست استریلیتی Sterility Test: این تست مطابق با استاندارد USP Ch.71 انجام میشود تا از عدم وجود هرگونه آلودگی میکروبی در محصول اطمینان حاصل شود.
- تست اندوتوکسین LAL Test: این تست طبق استاندارد USP Ch.12 انجام میشود و وجود اندوتوکسینهای باکتریایی را بررسی میکند.
- تست مایکوپلاسما با روش PCR: این تست با استفاده از روش PCR انجام میشود تا از عدم وجود مایکوپلاسما در محصول اطمینان حاصل شود.
اهمیت پایش محیطی در کنترل کیفیت
علاوه بر تستهای محصول، پایش محیطی نیز نقش کلیدی در کنترل کیفیت محصولات آسپتیک دارد. در شرکت فرآورده بافت ایرانیان، پایش هوا، سطوح و پرسنل مطابق با استانداردهای ISO 9001 و ISO 13485 انجام میشود. این پایشها شامل موارد زیر هستند:
- پایش هوا: بررسی تعداد ذرات معلق و میکروارگانیسمهای موجود در هوای محیط تولید.
- پایش سطوح: نمونهگیری از سطوح مختلف در محیط تولید برای شناسایی آلودگیهای احتمالی.
- پایش پرسنل: بررسی آلودگیهای میکروبی روی لباس و دستهای پرسنل تولید.
این پایشها به طور مداوم انجام میشوند تا از عدم آلودگی محیط تولید اطمینان حاصل شود.
کنترل کیفیت محصولات آسپتیک شامل آلوگرافتهای تاندون، مینیسک و دریچه قلب که با فرآوری آسپتیک و رعایت دقیق استانداردهای بینالمللی تولید میشوند. کنترل کیفیت این محصولات آلوگرافتی در شرکت فرآورده بافت ایرانیان (ریجن Regen) یک فرآیند چندمرحلهای و دقیق است که مطابق با استانداردهای بینالمللی انجام میشود. این فرآیند شامل کنترل میکروبی در حین تولید، آزمایشهای دقیق محصول نهایی و پایش محیطی است. در نهایت، در صورت تأیید نتایج آزمایشها، محصول برای ترخیص و استفاده آماده میشود.
- آلوگرفتهای تاندون و مینیسک: راهحلی ایمن و مؤثر برای جراحیهای ارتوپدی و پزشکی ورزشی
- آلوگرافت دریچه قلب: گزینهای ایدهآل برای ترمیم و جایگزینی دریچههای آسیبدیده در جراحیهای قلب و عروق
شرکت فرآورده بافت ایرانیان با بهکارگیری فناوری پیشرفته و رعایت دقیق استانداردهای بینالمللی، اطمینان حاصل میکند که محصولات آسپتیک این شرکت از بالاترین سطح کیفیت و ایمنی برخوردار هستند.
برای دریافت اطلاعات بیشتر درباره فرآیند کنترل کیفیت و محصولات می توانید از طریق قسمت ارتباط با ما در این وبسایت تماس باشید.
این مطلب چقدر مفید بود؟
برای امتیاز دادن، روی یک ستاره کلیک کنید!
میانگین امتیاز 5 / 5. تعداد امتیازها 2
شما اولین نفر باشید که امتیاز می دهید!
مطالب مرتبط

مشاوره رایگان
به مشاوره نیاز دارید؟
کادر حرفه ای و تخصصی شرکت فرآورده بافت ایرانیان آماده راهنمایی شما عزیزان می باشند